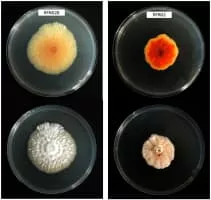

Sarocladium Oryzae
| Use attributes for filter ! | |
| Scientific name | Sarocladium oryzae |
|---|---|
| Higher classification | Sarocladium |
| Rank | Species |
| Phylum | Ascomycota |
| Family | Incertae sedis |
| Class | Ascomycetes |
| Date of Reg. | |
| Date of Upd. | |
| ID | 2194796 |
About Sarocladium Oryzae
Sarocladium oryzae is a plant pathogen causing the sheath rot disease of rice. In culture it produces 0. 3–0. 627 micrograms of helvolic acid and 0. 9–4. 8 micrograms of cerulenin per milliliter of culture medium. The level of helvolic acid correlated with a higher incidence of sheath rot disease.